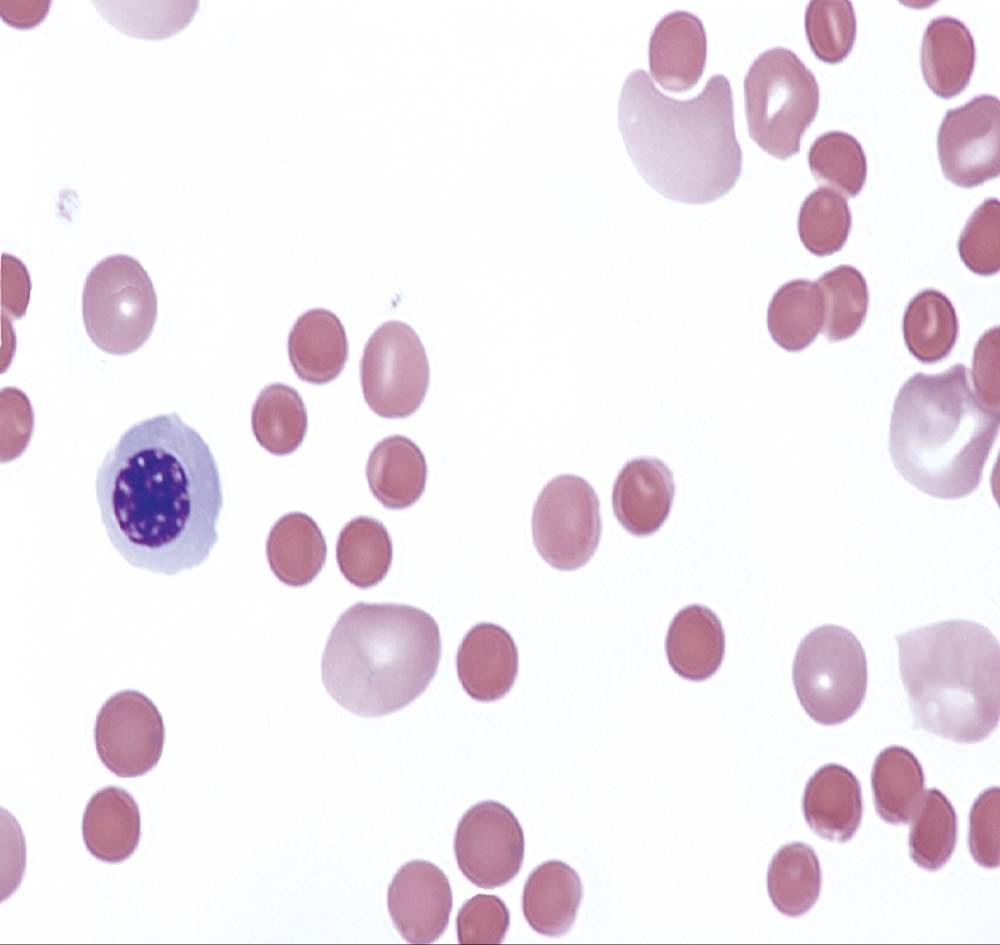
Image

Kim A. Przekop*
OUTLINE
Overview of Immune Hemolytic Anemias
Pathophysiology of Immune Hemolysis
Laboratory Findings in Immune Hemolytic Anemia
Autoimmune Hemolytic Anemia
Warm Autoimmune Hemolytic Anemia
Cold Agglutinin Disease
Paroxysmal Cold Hemoglobinuria
Mixed-Type Autoimmune Hemolytic Anemia
Drug-Induced Immune Hemolytic Anemia
Mechanisms of Drug-Induced Immune Hemolysis
Antibody Characteristics
Nonimmune Drug-Induced Hemolysis
Treatment
Alloimmune Hemolytic Anemias
Hemolytic Transfusion Reaction
Hemolytic Disease of the Fetus and Newborn
Objectives
After completion of this chapter, the reader will be able to:
1. Define immune hemolytic anemia and indicate the types of antibodies involved.
2. Compare and contrast the mechanisms of immune hemolysis mediated by immunoglobulin M (IgM) and IgG antibodies.
3. Describe typical laboratory findings in immune hemolytic anemia and the importance of the direct antiglobulin test (DAT).
4. Compare and contrast four types of autoimmune hemolytic anemia in terms of the immunoglobulin class involved, the temperature for optimal reactivity of the autoantibody, the proteins detected by the DAT on the patient’s red blood cells, the presence or absence of complement activation, the type and site of hemolysis, and the specificity of the autoantibody.
5. Relate results of the DAT to the pathophysiology and clinical findings in autoimmune hemolytic anemia.
6. Describe three mechanisms of drug-induced immune hemolysis.
7. Compare and contrast the pathophysiology of immune hemolysis due to drug-dependent and drug-independent antibodies, including the related laboratory findings.
8. Describe two types of hemolytic transfusion reactions, the usual immunoglobulin class involved, the typical site of hemolysis, and important laboratory findings.
9. Describe the cause, pathophysiology, and laboratory findings in Rh and ABO hemolytic disease of the fetus and newborn (HDFN).
10. Given a patient history and results of a complete blood count, peripheral blood film examination, pertinent biochemical tests on serum and urine, and the direct and indirect antiglobulin tests, determine the type of immune hemolysis.
CASE STUDY
After studying the material in this chapter, the reader should be able to respond to the following case study:
A 37-year-old man sought medical attention from his general practitioner for malaise, shortness of breath, and difficulty concentrating for the past five days. Physical examination revealed an otherwise healthy adult with tachycardia (faster than normal heart rate). There was no significant past medical history and the patient was not taking any medications. The physician ordered a complete blood count (CBC), urinalysis, comprehensive metabolic panel (CMP), and electrocardiogram (EKG). The following are the patient’s key laboratory results:
|
Patient Results |
Reference Interval |
|
|
WBC (×109/L) |
12.4 (corrected) |
3.6–10.6 |
|
HGB (g/dL) |
7.1 |
14.0–18.0 |
|
MCV (fL) |
105.4 |
80.0–100.0 |
|
MCHC (g/dL) |
36.3 |
32.0–36.0 |
|
RDW (%) |
17.3 |
11.5–14.5 |
|
PLT (×109/L) |
325 |
150–450 |
|
Reticulocytes (%) |
18.1 |
0.5–2.5 |
|
Neutrophils (%) |
72 |
50–70 |
|
Bands (%) |
10 |
0–5 |
The EKG was normal. The CBC instrument printout flagged for nucleated red blood cells (and corrected the WBC for them), 3+ anisocytosis, and reticulocytosis. The peripheral blood film had moderate spherocytes, moderate polychromasia, few macrocytes, 3+ anisocytosis, and 15 nucleated red blood cells/100 WBCs (Figure 26-1). Occasional schistocytes and neutrophilia with a slight left shift were also observed on the blood film (not shown in figure). The urinalysis report included 2+ protein, 2+ blood, increased urobilinogen, with 0 to 5 RBCs seen on the microscopic exam. The patient’s serum was moderately icteric, and the total serum bilirubin was increased. The patient was admitted for further testing. The serum haptoglobin was decreased, the serum indirect (unconjugated) bilirubin and lactate dehydrogenase (LD) were elevated, and urine hemosiderin was positive.
A type and screen was ordered. The antibody screen was negative at the immediate spin and 37° C incubation phase but showed 3+ agglutination in the antihuman globulin (AHG) phase for all panel cells and the autocontrol. The direct antiglobulin test (DAT) showed 3+ agglutination with polyspecific AHG and monospecific anti-IgG but was negative with monospecific anti-C3b/C3d (complement). An acid elution was performed on the patient’s RBCs, and the eluate showed 2+ reactions with all panel cells and autocontrol at the AHG phase. The patient was diagnosed with warm autoimmune hemolytic anemia (WAIHA) and started on 1 mg/kg/d prednisone until the hemoglobin reached 10.0 g/dL (2 weeks of treatment). The patient was continued on prednisone for 4 months with slowly decreasing levels of the drug. He also received bisphosphonates, vitamin D, and calcium to combat the ill effects of prednisone. At 3 weeks postdiagnosis, the spherocytes disappeared, the urinalysis was normal, and the DAT was negative.
1. Explain why the WBC count, MCV, RDW, and reticulocyte count results were elevated.
2. Describe the immune mechanism that caused the spherocytosis, and explain why spherocytes have a shortened life span.
3. Relate the chemistry, urinalysis, and blood bank results with the pathophysiology of the patient’s anemia.
4. Explain why the treatment was effective, and explain if the patient’s WAIHA was acute or chronic.
FIGURE 26-1 Wright-stained peripheral blood film from the patient in the case study (×1000).
Overview of immune hemolytic anemias
Immune hemolytic anemia and nonimmune hemolytic anemia are the two broad categories comprising the extrinsic hemolytic anemias, disorders in which red blood cells (RBCs) are structurally and functionally normal, but a condition outside of the RBCs causes premature hemolysis. The nonimmune extrinsic hemolytic anemias are the result of physical or mechanical injury to the RBCs and are covered in Chapter 25. The immune hemolytic anemias are conditions in which RBC survival is shortened due to an antibody-mediated mechanism. The antibody may be an autoantibody (directed against a self RBC antigen), an alloantibody (directed against an RBC antigen of another person), or an antibody directed against a drug (or its metabolite) taken by the patient. Some antibodies are able to activate the classical complement pathway, which results in the attachment of activated complement proteins to the RBC membrane. RBCs with bound antibody or complement are prematurely removed from the circulation extravascularly by macrophages (due to their receptors for complement and the Fc component of antibody), intravascularly by complement-mediated hemolysis, or by a combination of both mechanisms.1Anemia develops when the amount of hemolysis exceeds the ability of the bone marrow to replace the RBCs that are destroyed. The degree of anemia varies from asymptomatic and mild to severe and life-threatening.
The immune hemolytic anemias may be classified into the following groups: autoimmune hemolytic anemia, drug-induced immune hemolytic anemia, and alloimmune hemolytic anemia ().Box 26-11, 2 It is important to determine the cause of an immune hemolytic anemia so that the appropriate therapy can be administered to the patient.
BOX 26-1
Classification of Immune Hemolytic Anemias
Autoimmune hemolytic anemia
Warm autoimmune hemolytic anemia (WAIHA)
Idiopathic
Secondary
Lymphoproliferative disorders
Nonlymphoid neoplasms
Collagen-vascular disease
Immunodeficiency disorders
Viral infections
Cold agglutinin disease (CAD)
Idiopathic
Secondary
Acute: infections (Mycoplasma pneumoniae, infectious mononucleosis, other viruses)
Chronic: lymphoproliferative disorders
Paroxysmal cold hemoglobinuria (PCH)
Idiopathic
Secondary
Viral infections
Syphilis
Mixed-type autoimmune hemolytic anemia
Drug-induced immune hemolytic anemia (DIIHA)
Drug dependent
Drug independent
Alloimmune hemolytic anemias
Hemolytic transfusion reaction (HTR)
Hemolytic disease of the fetus and newborn (HDFN)
Pathophysiology of immune hemolysis
In immune hemolysis an antibody binds to an antigen on the surface of RBCs, which signals premature removal of those cells from the circulation through extravascular or intravascular hemolysis (Chapter 23). The two classes or isotypes of antibodies involved in most immune hemolytic anemias are immunoglobulin G (IgG) and M (IgM). IgG is a monomer in a Y-like structure with two identical heavy chains (γ H chains) and two identical light chains (either κ or λ) connected by disulfide bonds.3 At the top of the Y-like structure are two antigen-binding (Fab) domains, each formed from the N-terminus of the variable domain of one light and one heavy chain. IgG has one Fc domain (the stem of the Y) consisting of the C-terminus of the two heavy chains (Figure 26-2). IgM is a pentamer consisting of five monomeric units connected by disulfide linkages at the C-termini of their heavy chains (μ H chains).3, 4 Because the composition, structure, and size of IgG and IgM are different, their properties and mechanisms in mediating hemolysis are also different.

FIGURE 26-2 Schematic of an IgG molecule consisting of two heavy chains and two light chains. Note the antigen binding sites at the amino (NH2) end formed by the variable region (Fv) of one heavy chain and one light chain. Note the Fc region at the carboxyl (COOH) end of the heavy chains. The chains are held together by disulfide linkages. Source: (From McPherson RA, Massey HD. Laboratory Evaluation of Immunoglobulin Function and Humoral Immunity. In Henry’s Clinical Diagnosis and Management by Laboratory Methods, ed 22. Philadelphia, 2011, Saunders, an imprint of Elsevier.)
The classical complement pathway is an important mediator of immune hemolysis. The major proteins of the classical complement pathway are designated C1 through C9, and their components or fragments are designated with lowercase suffixes. The first protein, C1, has three components: C1q, C1r, and C1s. After an antibody binds to an antigen on the RBC surface, C1q must bind to two adjacent Fc domains to activate the pathway.4 Theoretically only one IgM molecule is needed for complement activation due to its larger pentameric structure with five Fc domains; however, at least two molecules of monomeric IgG in close proximity are required for C1q attachment.4 Therefore, IgM antibodies are highly effective in activating complement, whereas IgG antibodies are unable to activate the pathway unless there is a sufficient number of IgG molecules on the RBC surface.4, 5 In addition, subclasses IgG1 and IgG3 have high binding affinity for C1q, while subclasses IgG2 and IgG4 have minimal ability to bind complement.4, 5
The binding of C1q to adjacent Fc domains requires calcium and magnesium ions and activates C1r, which then activates C1s. This activated C1q-C1r-C1s complex is an enzyme that cleaves C4 and then C2, which results in the binding of a small number of C4bC2a complexes to the RBC membrane. The C4bC2a complex is an active C3 convertase enzyme that cleaves C3 in plasma; the result is the binding of many C3b molecules to C4bC2a on the RBC surface. The last phase of the classical pathway occurs when C4bC2aC3b converts C5 to C5b, which combines with C6, C7, C8, and multiple C9s to form the membrane attack complex (MAC). The MAC resembles a cylinder that inserts into the lipid bilayer of the membrane, forming a pore that allows water and small ions to enter the cell, causing lysis ().Figure 26-33 Negative regulators inhibit various complement proteins and complexes in the pathway to prevent uncontrolled activation and excessive hemolysis.1, 3, 4

FIGURE 26-3 Diagram of the classical pathway of complement activation. C1q is activated by binding to adjacent Fc domains of immunoglobulin bound to RBC antigen. C1q activates C1r; C1r activates C1s which forms the complex, C1qC1rC1s. The complex activates C2 and C4 to form the C4bC2a complex (C3 convertase) on the membrane. The complex converts C3 to many C3b molecules on the membrane. If there is no further activation, C3b will degrade to C3d on the membrane, which can be detected by polyspecific antihuman globulin (AHG). C3b can also form the complex C4bC2aC3b or C5 convertase, which converts C5 to C5b on the membrane. C5b forms the membrane attack complex, C5bC6C7C8C9, which inserts into the bilipid layer, causing lysis.
Hemolysis mediated by IgM antibodies requires complement and can result in both extravascular and intravascular hemolysis.5 When IgM molecules attach to the RBC surface in relatively low density, complement activation results in C3b binding to the membrane, but complement inhibitors prevent full activation of the pathway to the terminal membrane attack complex.1, 5 C3b-sensitized RBCs are destroyed by extravascular hemolysis, predominantly by macrophages (Kupffer cells) in the liver, which have C3b receptors. Some of the C3b on the RBCs can be cleaved, however, which leaves the C3d fragment on the cell. RBCs sensitized with only C3d are not prematurely removed from circulation because macrophages lack a C3d receptor.5 In severe cases of immune hemolysis involving heavy sensitization of RBCs with IgM antibody, significantly more complement is activated, which overwhelms the complement inhibitors. In these cases, complement activation proceeds from C1 to C9 and results in rapid intravascular hemolysis.5
Hemolysis mediated by IgG antibodies occurs with or without complement and predominantly by extravascular mechanisms.5 RBCs sensitized with IgG are removed from circulation by macrophages in the spleen, which have receptors for the Fc component of IgG1 and IgG3.1, 5 IgG antibodies are not efficient in activating complement, and intravascular hemolysis by full activation of complement from C1 to C9 is rare (except with anti-P in paroxysmal cold hemoglobinuria).5 However, if there is a high density of IgG1 or IgG3 bound to antigens on the RBCs, some complement is activated and C3b binds to the membrane. If both IgG and C3b are on the RBC membrane, there is faster clearance from the circulation by macrophages in both the spleen and the liver.1, 5 Often, IgG-sensitized RBCs are only partially phagocytized by macrophages, which results in the removal of some membrane. Spherocytes are the result of this process, and they are the characteristic cell of IgG-mediated hemolysis.5 The spherocytes are eventually removed from circulation by entrapment in the red pulp of the spleen (splenic cords), where they are rapidly phagocytized by macrophages (Chapter 8).5 The mechanisms of immune hemolysis are summarized in Table 26-1.
TABLE 26-1
Major Mechanisms of Immune Hemolysis
|
IgM Mediated |
IgG Mediated |
|
|
Extravascular hemolysis |
IgM activation of classical complement pathway from C1 to C3b only; clearance of C3b-sensitized RBCs by macrophages mainly in liver |
Clearance of IgG-sensitized RBCs by macrophages mainly in spleen |
|
Intravascular hemolysis |
Full IgM activation of classical complement pathway from C1 to C9 and direct RBC lysis; requires high-density IgM on RBCs to overcome complement inhibitors |
Full IgG activation of classical complement pathway from C1 to C9 and direct RBC lysis; requires very high-density IgG on RBCs for activation and to overcome complement inhibitors; uncommon |
* IgG3 and IgG1 are most efficient in complement activation.
Ig, Immunoglobulin; RBC, red blood cell.
Laboratory findings in immune hemolytic anemia
Laboratory findings in immune hemolytic anemia are similar to the findings in other hemolytic anemias and include decreased hemoglobin; increased reticulocyte count; increased levels of indirect serum bilirubin and lactate dehydrogenase; and decreased serum haptoglobin level. If the hemolysis is predominantly intravascular, or the extravascular hemolysis is severe, the haptoglobin level will be moderately to severely decreased, plasma hemoglobin will be increased, and the patient may have hemoglobinuria or even hemosiderinuria (in cases of chronic hemolysis) (Chapter 23). The mean cell volume (MCV) may be increased due to the reticulocytosis and RBC agglutination (if present). Leukocytosis and thrombocytosis may occur along with the increased erythroid proliferation in the bone marrow.1 Findings on the peripheral blood film include polychromasia (due to the reticulocytosis), spherocytes (due to IgG-mediated membrane damage by macrophages), and occasionally RBC agglutination.5 Nucleated RBCs, fragmented RBCs or schistocytes, and erythrophagocytosis (phagocytes engulfing RBCs) may also be observed on the peripheral blood film.1
To determine if the hemolysis is due to an immune mechanism, a direct antiglobulin test (DAT) is performed. The DAT detects in vivo sensitization of the RBC surface by IgG, C3b, or C3d.2 In the DAT procedure, polyspecific antihuman globulin (AHG) is added to saline-washed patient RBCs. Polyspecific AHG has specificity for the Fc portion of human IgG and complement components C3b and C3d; agglutination will occur if a critical number of any of these molecules is present on the RBC surface (Figure 26-4).2 If the DAT result is positive with polyspecific AHG, then the cells are tested with monospecific anti-IgG and anti-C3b/C3d to identify the type of sensitization. If IgG is detected on the RBCs, elution procedures are used to remove the antibody from the RBCs for identification.

FIGURE 26-4 Graphic representation of the direct and indirect antihuman globulin reaction. A, The direct antiglobulin test (DAT) detects IgG antibodies that are bound to corresponding antigens on the patient’s red blood cells in vivo. It does not require an incubation step. B, The indirect antiglobulin test (IAT) requires a 37° C incubation step to bind IgG antibodies (from patient’s serum or from typing reagents) to corresponding antigens on red blood cells in vitro. Polyspecific antihuman globulin (AHG) is a mixture of antibodies to IgG and complement components C3d/C3b. The anti-IgG produces agglutination by binding to the Fc domain of immunoglobulin G (IgG) antibodies that are bound to antigens on the red blood cell membranes. Similarly, the anti-C3d/C3b produces agglutination by binding to the respective complement components if present on the red blood cell membranes (reaction not shown). Monospecific AHG has specificity for either IgG or C3b/C3d. Although AHG is depicted as an IgG antibody in the figure above, in some reagents it can be an IgM isotype.
The specificity of the IgG antibody may be determined by assessing the reaction of the eluate with screening and panel reagent RBCs (RBCs genotyped for the major RBC antigens) using the indirect antiglobulin test(IAT) (Figure 26-4). Identification of any circulating alloantibodies or autoantibodies by the indirect antiglobulin test is also important in the investigation.2 The DAT result may be negative in patients with some immune hemolytic anemias.2 In addition, other disorders beside immune hemolytic anemia can cause a positive DAT finding.2 Therefore, diagnosis of immune hemolytic anemia cannot rely solely on the DAT and must take into account the patient history; symptoms; recent medications; previous transfusions; coexisting conditions, including pregnancy; and the results of the applicable hematologic, biochemical, and serologic tests.2, 5
Autoimmune hemolytic anemia
Autoimmune hemolytic anemia (AIHA) is a rare disorder characterized by premature RBC destruction and anemia caused by autoantibodies that bind the RBC surface with or without complement activation. AIHA can affect both children and adults, and its annual incidence is estimated to be between 1 and 3 per 100,000 individuals.6 In children, more males are affected, but in adults, more females are affected.6Autoantibodies may arise as a result of immune system dysregulation and loss of immune tolerance, exposure to an antigen similar to an autoantigen, B-lymphocyte neoplasm, or other unknown reason.1,6 The type, amount, and duration of antigen exposure and genetic and environmental factors may also contribute to the development of autoantibodies.5 The anemia can be mild or severe, and the onset can be acute or gradual. The severity of the anemia depends on the autoantibody characteristics (titer, ability to react at 37° C, ability to activate complement, and specificity and affinity for the autoantigen), antigen characteristics (density on RBCs, immunogenicity), as well as patient factors (age, ability of the bone marrow to compensate for the hemolysis, function of macrophages, complement proteins and regulators, and underlying conditions).1, 6
The autoimmune hemolytic anemias may be divided into four major categories based on the characteristics of the autoantibody and the mechanism of hemolysis: warm autoimmune hemolytic anemia, cold agglutinin disease, paroxysmal cold hemoglobinuria, and mixed-type autoimmune hemolytic anemia ().Table 26-22, 5, 6
TABLE 26-2
Characteristics of Autoimmune Hemolytic Anemias
|
Warm Autoimmune Hemolytic Anemia |
Cold Agglutinin Disease |
Paroxysmal Cold Hemoglobinuria |
Mixed-Type Autoimmune Hemolytic Anemia |
|
|
Immunoglobulin class |
IgG (rarely IgM, IgA) |
IgM |
IgG |
IgG, IgM |
|
Optimum reactivity temperature of autoantibody |
37° C |
4° C; reactivity extends to > 30° C |
4° C |
4°–37° C |
|
Sensitization detected by direct antiglobulin test |
IgG or IgG + C3d; only C3d uncommon |
C3d |
C3d |
IgG and C3d |
|
Complement activation |
Variable |
Yes |
Yes |
Yes |
|
Hemolysis |
Extravascular primarily |
Extravascular; rarely intravascular |
Intravascular |
Extravascular and intravascular |
|
Autoantibody specificity |
Panreactive or Rh complex; rarely specific Rh or other antigen |
I (most), i (some), Pr (rare) |
P |
Panreactive; unclear specificity |
Ig, Immunoglobulin.
Warm autoimmune hemolytic anemia
Warm autoimmune hemolytic anemia (WAIHA) is the most commonly encountered autoimmune hemolytic anemia, comprising up to 70% of cases.5 The autoantibodies causing WAIHA react optimally at 37° C, and the vast majority of them are IgG.1 WAIHA may be classified as idiopathic or secondary. In patients with idiopathic WAIHA, the etiology is unknown. Secondary WAIHA may occur in many conditions such as lymphoproliferative diseases (chronic lymphocytic leukemia, B-lymphocytic lymphomas, and Waldenström macroglobulinemia), nonlymphoid neoplasms (thymoma and cancers of the colon, kidney, lung, and ovary), autoimmune disorders (rheumatoid arthritis, scleroderma, polyarteritis nodosa, Sjögren syndrome, and systemic lupus erythematosus), immunodeficiency disorders, and viral infections.1, 5
The onset of WAIHA is usually insidious, with symptoms of anemia (fatigue, dizziness, dyspnea), but some cases can be acute and life-threatening with fever, jaundice, splenomegaly, and hepatomegaly, especially in children with WAIHA secondary to viral infections.1, 5 Massive splenomegaly, lymphadenopathy, fever, petechiae, ecchymosis, or renal failure in adults suggests an underlying lymphoproliferative disorder.1, 5
Although most autoantibodies that cause WAIHA are IgG, rare cases involving IgA autoantibodies as well as cases with fatal outcomes caused by warm-reacting IgM antibodies have been reported.1, 2Hemolysis is predominantly extravascular in WAIHA, and cases of fulminant intravascular hemolysis are rare.5
The result of the DAT is positive in over 95% of patients, with approximately 85% of patients having IgG alone or both IgG and C3d on their RBCs, and 10% to 14% having C3d only.1, 2, 5 Between 1% and 4% of patients have a negative DAT result caused by IgA or IgM autoantibodies that are not detected by the polyspecific AHG; IgG or C3d in an amount below the reagent detection limit; dissociation of IgG antibodies with low avidity during the washing phase of the DAT; or by various technical errors.1, 2, 5 Therefore, a negative DAT result does not rule out autoimmune hemolytic anemia.
Warm autoantibodies are usually panreactive; that is, they will agglutinate all screening and panel cells, donor RBCs, and the patient’s own RBCs, so the specificity of the autoantibody is not apparent.2, 5 In some cases Rh complex specificity can be demonstrated.2, 5 Rarely, a specific autoantibody to an antigen in the Rh blood group system is identified. Autoantibodies to other antigens (such as LW, Jk, K, Di, Ge, Lu, M, N, S, U, Ena, and Wrb) are occasionally identified.2, 5 For most patients (approximately 80%) the autoantibody can be detected in the serum. Because the autoantibody is panreactive, it may mask reactions of alloantibodies with RBC panel cells. If an RBC transfusion is necessary, it is crucial to perform tests to determine if clinically significant alloantibodies are also present.5
Anemia in WAIHA can be mild or severe, with RBC life span sometimes reduced to 5 days or less.1 Laboratory findings for serum and urine reflect the predominantly extravascular hemolysis that occurs in IgG-mediated immune hemolysis. Polychromasia and spherocytes are the typical findings on the peripheral blood film (Figure 26-1). Occasionally the WAIHA is accompanied by immune thrombocytopenic purpura and a decreased platelet count, a condition known as Evans syndrome, which occurs primarily in children.6, 7
In symptomatic but non-life-threatening WAIHA, a glucocorticosteroid such as prednisone is the initial treatment of choice.1, 2, 8 Approximately 70% to 80% of patients show improvement with prednisone, but many adult patients need to be on a long-term maintenance dosage to remain asymptomatic.1, 8 Osteoporosis, osteonecrosis, and bone fracture, particularly of the lumbar spine, are serious side effects of long-term steroid use and occur in approximately 30% to 50% of patients.1 The highest loss of bone density occurs early in treatment, even at smaller steroid doses, and the risk of fracture increases by 75% during the first months of treatment.1 Patients should also receive bisphosphonates, vitamin D, and calcium according to the recommendation of the American College of Rheumatology.9
Splenectomy is an option in patients with chronic WAIHA who are refractive to prednisone therapy or require long-term, high-dose prednisone therapy; a favorable response is achieved in 50% to 75% of patients.1Immunosuppressive drugs, such as cyclophosphamide or azathioprine, are used for refractory WAIHA, but the side effects may be severe.1, 6, 8 Rituximab, a monoclonal anti-CD20 antibody that binds to the corresponding antigen found on B cells, has also been used extensively. It causes minimal side effects and produces a response rate of 17% to 100%, according to various published case reports.1, 8Hematopoietic stem cell transplantation (HSCT) has been used for severe, life-threatening autoimmune syndromes, including hemolytic anemia and Evans syndrome. Sources of the stem cells have been autologous, HLA-matched sibling, and cord blood, all of which carry lethal risks. In secondary WAIHA, successful management of the underlying condition often controls the hemolysis and anemia. WAIHA with a critically low hemoglobin level requires RBC transfusion. If the autoantibody has broad specificity, all RBC units may be incompatible with the autoantibody.1, 2, 5 In such cases a minimum volume of RBCs is given, and the patient is carefully monitored during the transfusion.
Cold agglutinin disease
Cold agglutinins are autoantibodies of the IgM class that react optimally at 4° C and are commonly found in healthy individuals. These nonpathologic cold agglutinins are polyclonal, occur in low titers (less than 1:64 at 4° C), and have no reactivity above 30° C.1, 5 Most pathologic cold agglutinins are monoclonal, occur at high titers (greater than 1:1000 at 4° C), and are capable of reacting at temperatures greater than 30° C.2Because pathologic cold agglutinins can react at body temperature, they may induce cold agglutinin disease (CAD). Cold agglutinins that are able to bind RBC antigens near or at 37° C (high thermal amplitude) cause more severe symptoms.1, 10, 11 CAD has recently been recognized as a clonal lymphoproliferative B cell disorder.6, 10 It comprises approximately 15% to 20% of the cases of autoimmune hemolytic anemia.6
In CAD, the IgM autoantibody binds to RBCs after exposure to the cold, particularly in the peripheral circulation and the vessels of the skin, where temperatures can drop to 30° C.11 During the brief transit through these colder areas, IgM autoantibodies activate the classical complement pathway.10 When the RBCs return to the central circulation, the IgM antibody dissociates, but C3b components remain on the cell.2,10 Hemolysis is predominantly extravascular by hepatic macrophages, which have receptors for C3b.1, 10 However, if the autoantibody has a high thermal amplitude or there is a deficiency in complement regulatory proteins, full complement activation and intravascular hemolysis can occur.2, 12
Acute CAD occurs secondary to Mycoplasma pneumoniae infection, infectious mononucleosis, and other viral infections. These cold agglutinins are polyclonal IgM, with a normal distribution of κ and λ light chains.2, 5 Chronic CAD is a rare hemolytic anemia that typically occurs in middle-aged and elderly individuals, and the autoantibody is usually monoclonal IgM with κ light chains.6, 10, 11 In a study of 86 patients with chronic CAD by Berentsen and colleagues, the median age at onset was 67 years, with the median age at death reported to be 82 years.10 Chronic CAD can be idiopathic, with no known cause, or secondary due to lymphoproliferative neoplasms such as B-lymphocytic lymphomas, Waldenström macroglobulinemia, or chronic lymphocytic leukemia.10
Clinical manifestations are variable in chronic CAD. Most patients have a mild anemia with a hemoglobin result ranging from 9 to 12 g/dL, but others can develop life-threatening anemia with hemoglobin levels falling below 5 g/dL, especially after exposure to cold temperatures.5, 11, 13 Individuals often experience fluctuations between mild and severe symptoms, and approximately half of those affected require transfusions over the course of the disease.10 Symptoms include fatigue, weakness, dyspnea, pallor (due to the anemia), and acrocyanosis.11 Acrocyanosis is a bluish discoloration of the extremities (fingers, toes, feet, earlobes, nose) due to RBC autoagglutination, which causes local capillary stasis.1, 2, 11 Some patients also have episodes of hemoglobinuria, especially after exposure to cold temperatures.2, 11 In contrast, patients with acute CAD may have mild to severe hemolysis that appears abruptly within 2 to 3 weeks after the onset of infectious mononucleosis, other viral infection, or M. pneumoniae infection, but it resolves spontaneously within days to a few weeks.11
The DAT result is positive with polyspecific AHG because of the presence of C3d on the RBC surface. The specificity of the cold agglutinin is most often anti-I but can be anti-i or, very rarely, anti-Pr.2, 12Virtually all adult RBCs are positive for the I antigen, so anti-I will agglutinate all screening and panel cells, donor RBCs, and the patient’s own RBCs at room temperature and higher, depending on the thermal amplitude of the autoantibody. Anti-I will show weaker or negative reactions with cord RBCs (cord cells are negative for I antigen but positive for i antigen).2
A cold agglutinin method is used to determine the titer of the antibody at 4° C. Pathologic cold agglutinins can reach titers of 1:10,000 to 1:1,000,000 at 4° C.1, 5 Blood specimens for cold agglutinin testing must be maintained at 37° C after collection to prevent the binding of the autoantibody to the patient’s own RBCs, which can falsely decrease the antibody titer in the serum. Alternatively, a sample anticoagulated with EDTA can be warmed for 15 minutes at 37° C to dissociate autoabsorbed antibody prior to determining the titer.
When a high-titer cold agglutinin is present, an EDTA-anticoagulated blood specimen can show visible agglutinates in the tube at room temperature or below.1 The agglutination can also be observed on a peripheral blood film (Figure 26-5). Blood specimens from patients with cold agglutinins must be warmed to 37° C for 15 minutes before complete blood count analysis by automated hematology analyzers. RBC agglutination grossly elevates the mean cell volume, reduces the RBC count, and has unpredictable effects on other indices (Chapter 15). When the sample is warmed to 37° C, the antibody dissociates from the RBCs, and agglutination usually disappears. If not, a new specimen is collected and maintained at 37° C for the entire time before testing. To avoid agglutination on a peripheral blood film, the slide can also be warmed to 37° C prior to the application of blood. Cold agglutinins can also interfere with ABO typing.2

FIGURE 26-5 Wright-stained peripheral blood film showing red blood cell agglutination (×500).
Acute CAD associated with infections is self-limiting, and the cold agglutinin titers are usually less than 1:4000.11 If the hemolysis is mild, no treatment is required; however, patients with severe hemolysis require transfusion and supportive care.11 Patients with chronic CAD and mild anemia are regularly monitored and advised to avoid cold temperatures.1 In chronic CAD with moderate to severe symptoms, rituximab produces partial remission in about half of patients due to its targeting and ultimate destruction of the B-lymphocytes containing the CD-20 antigen, but median remission is less than a year.14 In a 2010 study by Berentsen and colleagues, a combination of rituximab with fludarabine resulted in a better response rate (76%) and median duration of remission (66 months); however, hematologic toxicity was reported in almost half of the patients.13 Even with the occasional severe side effects, rituximab is currently the best second-line treatment for CAD and primary AIHA, it can be given multiple times, and children tolerate it well. Plasmapheresis may be used in severe cases but provides only temporary benefit.1 Corticosteroid therapy and immunosuppressive therapy with cyclophosphamide and chlorambucil are not effective for most patients.11, 12 Splenectomy is also not effective because C3b-sensitized RBCs in IgM-mediated autoimmune hemolysis are cleared primarily by the liver.1, 5, 11
RBC transfusion is reserved for patients with life-threatening anemia or cardiovascular or cerebrovascular symptoms.1 If transfusion is needed, the presence of clinically significant alloantibodies must be ruled out.2 In CAD cases involving an autoantibody with wide thermal amplitude, detection of coexisting warm-reactive alloantibodies can be time-consuming and difficult. During transfusion, the patient is kept warm, small amounts of blood are given while the patient is observed for symptoms of a hemolytic transfusion reaction, and a blood warmer is used to minimize the in vivo reactivity of the cold autoantibody.1
Paroxysmal cold hemoglobinuria
Paroxysmal cold hemoglobinuria (PCH) is an acute form of cold-reactive hemolytic anemia. PCH can be idiopathic or secondary. Historically, secondary PCH was associated with late-stage syphilis, but now it is most commonly seen in young children after a viral respiratory infection.1, 2, 11 PCH is rare in adults. The prevalence of PCH has been reported to be as high as 32% to 40% of children with autoimmune hemolytic anemia, with a median age at presentation of 5 years.15, 16
The anti-P autoantibody, also called the Donath-Landsteiner antibody, is a complement-binding IgG hemolysin with specificity for the P antigen on RBCs. The anti-P autoantibody is biphasic in that at cold temperatures it binds to the P antigen on RBCs and partially activates complement (C1 to C4), but full complement activation (C3 through C9) and hemolysis occur only upon warming to 37° C.17 Exposure to cold temperatures is not required for the hemolytic manifestations in vivo, however, and the reasons for this have yet to be explained.2 The anti-P autoantibody binds RBC antigen optimally at 4° C and has a thermal amplitude of less than 20° C. At warmer temperatures, the anti-P autoantibody dissociates from the RBCs; the titer is usually less than 1:64.11
Children typically present with acute fever; malaise; and back, leg, and/or abdominal pain 1 to 2 weeks after an upper respiratory tract infection.11 Pallor, jaundice, and dark urine due to hemoglobinuria are frequently present.11 The abrupt onset of hemolysis causes a rapidly progressing and severe anemia, with hemoglobin levels often dropping below 5 gm/dL.11
Reticulocytosis is typical but can be preceded by reticulocytopenia.11 The peripheral blood film shows polychromasia and spherocytes, but schistocytes, nucleated RBCs, anisocytosis, poikilocytosis, and erythrophagocytosis can also be observed.11 At first, leukopenia may be present; later, leukocytosis occurs.11 In addition, laboratory findings typical for intravascular hemolysis are found. Because the anti-P autoantibody is dissociated from the RBCs at body temperature, the DAT result is usually positive for C3d only.2, 15
The classic Donath-Landsteiner test for anti-P is done by collecting blood samples in two tubes, one for the patient test and the other for the patient control.16 The patient test sample is incubated first at 4° C for 30 minutes (to allow anti-P binding to the P antigen and partial complement activation on the RBCs) and then at 37° C for 30 minutes (to allow full activation of the complement pathway to lysis). The patient control tube is kept at 37° C for both incubations (and a total of 60 minutes). After centrifugation the supernatant is examined for hemolysis. A positive test result for anti-P is indicated by hemolysis in the patient test sample incubated first at 4° C and then at 37° C and no hemolysis in the patient control sample kept at 37° C. In the control tube, the anti-P is not able to bind to antigen at 37° C, so complement is not activated and hemolysis does not occur.16 Initial test results may be falsely negative due to low complement and/or anti-P levels in the patient sample because of the brisk hemolysis in vivo.16 Incubating patient serum with complement and papain-treated compatible group O RBCs increases the sensitivity of the test in detecting anti-P. The enzyme treatment provides greater exposure of the P antigen on the RBC surface for antibody binding.16
PCH is severe but self-limiting and resolves in several days to a few weeks, with an excellent prognosis.1, 11, 15 In most patients, the anemia is severe and can be life-threatening, so transfusion is usually needed until the symptoms resolve. Because the anti-P autoantibody reacts only at lower temperatures and P antigen–negative blood is very rare, P-positive blood can be transfused.2
Mixed-type autoimmune hemolytic anemia
Mixed-type autoimmune hemolytic anemia occurs very infrequently.18 In this condition, the patient simultaneously develops an IgG autoantibody with optimum reactivity at 37° C (WAIHA) and a pathologic IgM autoantibody that reacts optimally at 0° C to 10° C but has a thermal amplitude of greater than 30° C (CAD).18 Patients with WAIHA and a nonpathogenic cold agglutinin (i.e., an agglutinin that does not react at a temperature greater than 20° C) should not be classified as having a mixed-type autoimmune hemolytic anemia because the cold agglutinin is not clinically significant.11
The hemolysis results from a combination of extravascular and intravascular mechanisms. The disease course appears to be chronic, with intermittent episodes of severe anemia.5, 11 The DAT results can be positive with IgG only, C3d only, or IgG and C3d.2 The warm autoantibody is typically panreactive with unclear specificity, whereas the cold-reacting antibody usually has anti-I specificity.5 Treatment is the same as that described for WAIHA.5
Drug-induced immune hemolytic anemia
Drug-induced immune hemolytic anemia (DIIHA) is very rare, with an estimated annual incidence of about 1 per million persons.19 This condition is suspected when there is a sudden decrease in hemoglobin after administration of a drug, clinical and biochemical evidence of extravascular or intravascular hemolysis, and a positive DAT result.20 Over 125 drugs have been reported to cause DIIHA, with the most common drug categories being antimicrobial, antiinflammatory, and antineoplastic drugs.21, 22 The most common drugs implicated in DIIHA in the last 10 years are cefotetan, ceftriaxone, trimethoprim, and piperacillin. Severe, even fatal, cases have been reported.19, 22-24
Mechanisms of drug-induced immune hemolysis
Various theories have been proposed to explain the mechanisms of DIIHA.19, 24 Three generally accepted mechanisms involve an antibody produced by the patient as a result of exposure to the drug and include drug adsorption, drug–RBC membrane protein immunogenic complex, and RBC autoantibody induction. A fourth mechanism, drug-induced nonimmunologic protein adsorption (NIPA), can result in a positive DAT result, but no drug or RBC antibody is produced by the patient. This mechanism is discussed at the end of this section.
1. Drug adsorption: The patient produces an IgG antibody to a drug. When the drug is taken by the patient, the drug binds strongly to the patient’s RBCs (see paragraph below on unifying theory). The IgG drug antibody binds to the drug attached to the RBCs, usually without complement activation. Because the offending antibody is IgG and is strongly attached to the RBCs via the drug, hemolysis is extravascular by splenic macrophages, which remove the antibody- and drug-coated RBCs from the circulation.
2. Drug–RBC membrane protein immunogenic complex: A drug binds loosely to an RBC membrane protein to form a drug–RBC protein immunogenic complex or epitope. The patient produces an IgM and/or IgG antibody that binds to the complex on the RBCs, and complement is fully activated, which causes acute intravascular hemolysis.
3. RBC autoantibody induction: A drug induces the patient to produce IgG warm-reactive autoantibodies against RBC self-antigens. These autoantibodies react at 37° C, and the laboratory findings are indistinguishable from those in WAIHA. Hemolysis is extravascular and is mediated by macrophages predominantly in the spleen.
Several authors have suggested that all drug-induced immune hemolysis is explained by a single mechanism, known as the unifying theory. This theory proposes that a drug interacts with the RBC membrane and generates multiple immunogenic epitopes that can elicit an immune response to the drug alone, to the drug–RBC membrane protein combination, or to an RBC membrane protein alone.2, 21, 25 Diagnosis of DIIHA can only be made if the antibody screen is positive and the RBC eluate contains an antibody.1
Antibody characteristics
Antibodies implicated in DIIHA can be divided into two general types: drug-dependent (most common) and drug-independent antibodies.2, 21 Some drugs are able to induce a combination of both types of antibodies.19, 24, 25
Drug-dependent antibodies
Drug-dependent antibodies only react in vitro when the suspected drug or its metabolite is present.2, 21 There are two types of drug-dependent antibodies:
1. Antibodies that react only with drug-treated cells:2 These are IgG drug antibodies that bind to the drug when it is strongly associated with the RBC surface (drug adsorption mechanism). Because they have bound IgG, the RBCs are cleared from the circulation extravascularly by macrophages in the spleen, and a hemolytic anemia gradually develops. Complement is not usually activated. If the DIIHA is not recognized, the patient may continue to take the drug to a point in which life-threatening anemia develops.2, 19 Examples of drugs that elicit antibodies in this category are penicillin and cyclosporin.2, 21 Laboratory features include a positive DAT reaction with anti-IgG, whereas the reaction with anti-C3b/C3d is usually negative. In the indirect antiglobulin test, the patient’s serum and an eluate of the patient’s cells react only with drug-treated RBCs and not with untreated RBCs.2
2. Antibodies that react only in the presence of the drug:2 These IgG and/or IgM antibodies bind to the drug or its metabolite only when it is weakly associated in a drug–RBC membrane protein complex (drug–RBC membrane protein immunogenic complex mechanism). The antibodies activate complement and trigger acute intravascular hemolysis that may progress to renal failure.2 Hemolysis occurs abruptly after short periods of drug exposure or upon readministration of the drug.19 Examples of drugs that elicit antibodies in this category are phenacetin, trimethoprim, quinine, and ciprofloxacin.2, 19, 22, 23 Laboratory features include a positive DAT reaction with anti-C3b/C3d and occasionally with anti-IgG. In the indirect antiglobulin test, the patient’s serum reacts with untreated, normal RBCs only in the presence of the drug.
Drug-independent antibodies
Drug-independent antibodies are IgG, warm-reactive, RBC autoantibodies induced by the drug (RBC autoantibody induction mechanism). These autoantibodies have the same serologic reactivity as those causing WAIHA, and they do not require the presence of the drug for in vitro reactivity. Hemolysis is extravascular, mediated by macrophages predominantly in the spleen, usually with a gradual onset of anemia. Examples of drugs that elicit antibodies in this category are fludarabine, methyldopa, and procainamide.2, 19, 21 Laboratory features include a positive DAT reaction with anti-IgG. In the indirect antiglobulin test, the patient’s serum and an eluate of the patient’s cells generally react at 37° C with all screening and panel RBCs and with the patient’s own RBCs.2
Nonimmune drug-induced hemolysis
In drug-induced nonimmunologic protein adsorption, the patient does not produce an antibody to the drug or to RBCs. The mechanism is also called the membrane modification method, because certain drugs such as high-dose clavulanate and cisplatin can alter the RBC membrane so that numerous proteins, including IgG and complement, adsorb onto the RBC surface.21, 24 This phenomenon results in a positive DAT finding, but only rarely has hemolysis been reported. The indirect antiglobulin test on the patient’s serum and an eluate of the patient’s RBCs yield negative results.2
Treatment
After a DIIHA is recognized and confirmed, the first treatment is to discontinue the drug. Most patients will gradually show improvement within a few days to several weeks.19 In cases in which a warm-reacting autoimmune antibody is present, the positive DAT result may persist for months after a hematologic recovery. If the anemia is severe, the patient may require RBC transfusion or plasma exchange.19 Regardless of mechanism, future episodes of DIIHA are prevented by avoidance of the drug.
Alloimmune hemolytic anemias
Hemolytic transfusion reaction
One of the most severe and potentially life-threatening complications of blood transfusion is a hemolytic transfusion reaction (HTR) due to immune-mediated destruction of donor cells by an antibody in the recipient. The offending antibody in the recipient may be IgM or IgG, complement may be partially or fully activated or not activated at all, and the hemolysis may be intravascular or extravascular, depending on the characteristics of the antibody. HTRs can have an acute or delayed onset.2
Acute hemolytic transfusion reaction
Acute hemolytic transfusion reactions (AHTRs) occur within minutes to hours of the initiation of a transfusion.26 The most common cause of AHTR is the accidental transfusion of ABO-incompatible donor red blood cells into a recipient. An example is the transfusion of group A red blood cells into a group O recipient. The recipient has preformed, non-RBC stimulated anti-A (IgM) that is capable of fully activating complement to C9 upon binding to the A antigen on donor red blood cells. There is rapid, complement-mediated intravascular hemolysis and activation of the coagulation system. ABO-incompatible transfusions are usually due to clerical error and have been estimated to occur in approximately 1 in 38,000 to 1 in 70,000 RBC transfusions.26 The severity of AHTR is variable and is affected by the infusion rate and volume of blood transfused.2, 27 AHTR carries an estimated mortality rate of 2%.26 AHTRs can occur due to incompatibilities involving other blood group systems, but these are rare.26
Symptoms of severe intravascular hemolysis found in ABO-related AHTRs begin within minutes or hours and may include chills, fever, urticaria, tachycardia, nausea and vomiting, chest and back pain, shock, anaphylaxis, pulmonary edema, congestive heart failure, and bleeding due to disseminated intravascular coagulation (DIC). The transfusion should be immediately terminated upon first appearance of symptoms. Treatment is urgent and includes an effort to prevent or correct shock, maintain renal circulation, and control the DIC.27
The immediate investigation of a suspected HTR includes a clerical check for errors, an examination of a posttransfusion blood specimen for hemolysis, and performance of the DAT on the RBCs in a posttransfusion specimen.26 If an AHTR occurred, hemoglobinemia and hemoglobinuria are detectable, and the DAT result is positive. DAT findings may be negative, however, if all the donor cells are lysed.26The hemoglobin and serum haptoglobin levels decrease, but the serum indirect bilirubin will not begin to rise until 2 to 3 days after the episode. The ABO and Rh typing, antibody screen, and cross-matching are repeated on the recipient and the donor blood to identify the blood group incompatibility. Coagulation tests such as D-dimer, fibrinogen, factors V and VIII, and platelet count can help reveal and assess the risk of DIC.2
Delayed hemolytic transfusion reaction
A delayed hemolytic transfusion reaction (DHTR) may occur days to weeks after transfusion as the titer of alloantibodies increases.2, 27 Often, the patient has been alloimmunized by a pregnancy or previous transfusion, but the antibody titer was below the level of serologic detection at the time of transfusion. The second exposure to the antigen results in an increase in titer (anamnestic response). The antibody is usually IgG, is reactive at 37° C, and may or may not be able to partially or fully activate complement. The antibodies most often implicated in DHTRs are directed against antigens in the Duffy and Kidd blood groups.26, 27 The patient’s antibody binds to the transfused RBCs, which leads to extravascular hemolysis, with or without complement activation. The principal signs are an inadequate posttransfusion hemoglobin increase, positive DAT results for IgG and/or C3d, morphologic evidence of hemolysis, and an increase in serum indirect bilirubin.25, 26 Management of DHTR includes monitoring of kidney function, especially in acutely ill patients.26
Hemolytic disease of the fetus and newborn
Hemolytic disease of the fetus and newborn (HDFN) occurs when an IgG alloantibody produced by the mother crosses the placenta into the fetal circulation and binds to fetal RBCs that are positive for the corresponding antigen. The IgG-sensitized fetal RBCs are cleared from the circulation by macrophages in the fetal spleen (extravascular hemolysis), and an anemia gradually develops. There is erythroid hyperplasia in the fetal bone marrow and extramedullary erythropoiesis in the fetal spleen, liver, kidneys, and adrenal glands.28 Many nucleated RBCs are released into the fetal circulation. If the anemia is severe in utero, it can lead to generalized edema, ascites, and a condition called hydrops fetalis, which is fatal if untreated.2, 28 Anti-Kell antibodies are an exception because they also cause anemia by suppressing fetal erythropoiesis.28
In Rh HDFN, which causes the highest number of fetal fatalities, an Rh (D)-negative mother has preformed anti-D antibodies (IgG, reactive at 37° C) from exposure to the D antigen either through immunization in a previous pregnancy with a D-positive baby or from previous transfusion of blood products with D-positive RBCs. In subsequent pregnancies, the anti-D crosses the placenta, and if the fetus is D positive, the anti-D binds to D antigen sites on the fetal RBCs. These anti-D–sensitized fetal RBCs are cleared from the circulation by macrophages in the fetal spleen, and anemia and hyperbilirubinemia develop. Amniocentesis is accurate at predicting severe fetal anemia, but it is an invasive procedure and carries some risk of fetal loss.28 If severe fetal anemia and HDFN due to anti-D is suspected, a percutaneous umbilical fetal blood sample can be obtained and tested for the hemoglobin level to determine the severity of the anemia; more recently, a noninvasive assessment of anemia can be done by ultrasound measurement of fetal cerebral flow.2, 28
Laboratory findings
ABO, Rh typing, and an antibody screen are performed on the mother when the fetus is between 10 and 16 weeks’ gestation, and again at 28 weeks’ gestation.28 The antibody screen during pregnancy detects antibodies other than those caused by ABO incompatibility.2 If the antibody screen is positive, an RBC panel is performed to identify the specificity of the antibody. Mothers with initial positive antibody screens are retested for an antibody screen every month until 28 weeks, then every two weeks thereafter; antibody titers are reported from each sample. Titration of the antibody does not predict the severity of HDFN; rather, it helps determine when to monitor for HDFN by additional methods, such as spectrophotometric analysis of amniotic fluid bilirubin.2, 28 After the first affected pregnancy, the antibody titer is no longer useful, and other means of monitoring the fetus are used, such as amniocentesis and ultrasonography.28
An unimmunized D-negative mother receives antenatal Rh immune globulin (RhIG) at 28 weeks’ gestation and again within 72 hours of delivery of a D-positive infant to prevent alloimmunization to the D antigen.2 Even one antenatal dose of 200 μg RhIG will reduce by half the risk of the mother developing anti-D antibodies and having a child with HDFN in the next pregnancy.29 Rh-negative women who experience spontaneous or induced abortion also receive Rh immune globulin.
At delivery, newborn testing is performed on umbilical cord blood. Neonates with Rh HDFN have a decreased hemoglobin level, increased reticulocyte count, and increased level of serum indirect bilirubin. The peripheral blood film shows polychromasia and many nucleated RBCs. ABO (only forward typing), Rh typing, and the DAT are also performed. The DAT result is positive for IgG, and anti-D can be demonstrated in an eluate of the infant’s RBCs.28
Treatment for the affected infant
Treatment for a fetus affected by HDFN may include intrauterine transfusion, whereby pooled hemolyzed blood is removed via amniocentesis from the fetal abdomen and replaced with a small amount of fresh red blood cells. This procedure can be used to correct fetal anemia and prevent hydrops fetalis.30 Cordocentesis is also utilized, whereby fresh red blood cells are injected into the umbilical vein. The survival rates of fetuses receiving transfusions are 85% to 90%; the risk of premature death from these procedures varies from 1% to 3%.30 After delivery, the neonate may need exchange transfusions and phototherapy to reduce the level of serum indirect bilirubin and prevent kernicterus (bilirubin accumulation in the brain).28 Prolonged postnatal anemia can be due to a slow decrease of maternal antibody in the newborn’s circulation; rare cases of prolonged anemia are documented in infants who received intrauterine transfusions.31, 32
Hemolytic disease of the fetus and newborn caused by other blood group antigens
ABO HDFN is more common than Rh disease and may occur during the first pregnancy. Unlike Rh disease, ABO disease is asymptomatic or produces mild hyperbilirubinemia and anemia. ABO HDFN is seen in some type A or B infants born to type O mothers who produce IgG anti-A and anti-B which are capable of crossing the placenta. The disease is milder than Rh HDFN likely because A and B antigens are poorly developed on fetal and newborn RBCs, and other cells and tissues express A and B antigens which reduces the amount of maternal antibody directed against fetal RBCs. The DAT result for the newborn with ABO HDFN is only weakly positive and may be negative. Spherocytes and polychromasia on the peripheral blood film are typical.2 Table 26-3 presents a comparison of HDFN caused by ABO and Rh incompatibility.
TABLE 26-3
Characteristics of Rh and ABO Hemolytic Disease of the Fetus and Newborn
|
Rh |
ABO |
|
|
Blood Groups |
||
|
Mother |
Rh (D) negative |
O |
|
Child |
Rh (D) positive |
A or B |
|
Severity of disease |
Severe |
Mild |
|
Jaundice |
Severe |
Mild |
|
Spherocytes on peripheral blood film |
Rare |
Usually present |
|
Anemia |
Severe |
If present, mild |
|
Direct antiglobulin test result |
Positive |
Negative or weakly positive |
HDFN can be caused by other IgG antibodies, particularly antibodies to the K, c, and Fya antigens.2 HDFN due to other blood group antibodies is rare.28, 33-36 Antibody screening in the first trimester can assist in identifying rare antibodies that can cause HDFN.37 Varying degrees of anemia, jaundice, and kernicterus are the adverse clinical outcomes in all forms of HDFN.
Summary
• The immune hemolytic anemias are classified into autoimmune hemolytic anemia, drug-induced immune hemolytic anemia, and alloimmune hemolytic anemia.
• Hemolysis mediated by IgM requires complement; hemolysis may be extravascular (mainly in the liver) if complement is partially activated to C3b, or intravascular if complement is fully activated to C9.
• Hemolysis mediated by IgG occurs with or without complement activation; IgG-sensitized RBCs are removed from the circulation by macrophages in the spleen; partial phagocytosis produces spherocytes, which are prematurely trapped in the spleen and phagocytized; IgG- and C3b-sensitized RBCs are removed by macrophages in the spleen and liver.
• Laboratory findings in immune hemolytic anemia include decreased hemoglobin level, increased reticulocyte count, increased levels of serum indirect bilirubin and lactate dehydrogenase, and decreased serum haptoglobin level. The peripheral blood film may show polychromasia, spherocytes (IgG-mediated hemolysis), or RBC agglutination (cold agglutinins). The DAT detects in vivo sensitization of RBCs by IgG and/or C3b/C3d.
• The classification of autoimmune hemolytic anemia includes warm autoimmune hemolytic anemia (WAIHA), cold agglutinin disease (CAD), paroxysmal cold hemoglobinuria (PCH), and mixed-type autoimmune hemolytic anemia.
• WAIHA is the most common form of autoimmune hemolytic anemia and involves IgG autoantibodies with optimum reactivity at 37° C. The anemia varies from mild to severe, and characteristic morphologic features on the peripheral blood film are polychromasia and spherocytes.
• CAD is caused by an IgM autoantibody with optimum reactivity at 4° C and a thermal amplitude of greater than 30° C. RBC agglutination may be observed on a peripheral blood film, and agglutinates may cause interference with the complete blood count analysis on automated hematology analyzers.
• Paroxysmal cold hemoglobinuria (PCH) is due to a biphasic IgG autoantibody with anti-P specificity. The antibody binds to the P antigen on the RBCs and partially activates complement at 4° C; complete complement activation and hemolysis occur upon warming the sample to 37° C.
• In drug-induced immune hemolytic anemia (DIIHA), the patient produces antibodies to (1) a drug only, (2) a complex of a drug loosely bound to an RBC membrane protein, or (3) an RBC membrane protein only. In vitro reactions of antibodies in DIIHA may be drug-dependent or drug-independent.
• Acute hemolytic transfusion reactions (AHTRs) occur within minutes to hours after the start of an RBC transfusion and most often involve transfusion of ABO-incompatible blood; the hemolysis is predominantly intravascular. Delayed hemolytic transfusion reactions (DHTRs) may occur days or weeks after the transfusion and represent an anamnestic response to a donor red blood cell antigen; the hemolysis is usually extravascular.
• Hemolytic disease of the fetus and newborn (HDFN) occurs when an IgG alloantibody produced by the mother crosses the placenta into the fetal circulation and binds to fetal RBCs that are positive for the corresponding antigen. The IgG-sensitized fetal RBCs are cleared from the circulation by macrophages in the fetal spleen, and an anemia gradually develops; the usual laboratory findings in the neonate are anemia, hyperbilirubinemia, and a positive direct antiglobulin test (DAT) result.
• ABO HDFN is more common than Rh HDFN and produces no symptoms or mild anemia. Rh HDFN due to anti-D results in severe anemia. Antenatal administration of Rh immune globulin to a D-negative mother when the fetus is at 28 weeks’ gestation and within 72 hours after delivery of a D-positive baby prevents immunization to the D antigen.
Now that you have completed this chapter, go back and read again the case study at the beginning and respond to the questions presented.
Review questions
Answers can be found in the Appendix.
1. Immune hemolytic anemia is due to a(n):
a. Structural defect in the RBC membrane
b. Allo- or autoantibody against an RBC antigen
c. T cell immune response against an RBC antigen
d. Obstruction of blood flow by intravascular thrombi
2. The pathophysiology of immune hemolysis with IgM antibodies always involves:
a. Complement
b. Autoantibodies
c. Abnormal hemoglobin molecules
d. Alloantibodies
3. In hemolysis mediated by IgG antibodies, which abnormal RBC morphology is typically observed on the peripheral blood film?
a. Spherocytes
b. Nucleated RBCs
c. RBC agglutination
d. Macrocytes
4. The most important finding in the diagnostic investigation of a suspected autoimmune hemolytic anemia is:
a. Detection of a low hemoglobin and hematocrit
b. Observation of hemoglobinemia in a specimen
c. Recognition of a low reticulocyte count
d. Demonstration of IgG and/or C3d on the RBC surface
5. In autoimmune hemolytic anemia, a positive DAT is evidence that an:
a. IgM antibody is in the patient’s serum
b. IgG antibody is in the patient’s serum
c. IgM antibody is sensitizing the patient’s red blood cells
d. IgG antibody is sensitizing the patient’s red blood cells
6. Which of the following is NOT a mechanism of drug-induced hemolytic anemia?
a. Drug adsorption on red blood cell membrane
b. Drug–RBC membrane protein immunogenic complex
c. RBC autoantibody induction
d. IgM autoantibody sensitization of RBCs after exposure to the cold
7. Which of the following describes a penicillin-induced AIHA?
a. Extravascular hemolysis, positive DAT with IgG, gradual anemia
b. Intravascular, possible renal failure, positive DAT with C3d
c. Rare hemolysis, positive DAT with IgG
d. Intravascular hemolysis, positive DAT with IgG
8. Which one of the following statements is true about DHTR:
a. It is usually due to an ABO incompatibility
b. Hemoglobinemia and hemoglobinuria frequently occur
c. It is due to an anamnestic response after repeat exposure to a blood group antigen
d. The DAT yields a positive result for C3d only
9. Chronic secondary CAD is most often associated with:
a. Antibiotic therapy
b. M. pneumoniae infection
c. B cell malignancies
d. Infectious mononucleosis
10. A 63-year-old man is being evaluated because of a decrease in hemoglobin of 5 gm/dL after a second cycle of fludarabine for treatment of chronic lymphocytic leukemia. The patient’s DAT result is strongly positive for IgG only, and antibody testing on his serum and an eluate of his RBCs yield positive results with all panel cells and the patient’s own cells. This suggests which mechanism of immune hemolysis for this patient?
a. Drug-RBC membrane protein complex
b. Drug adsorption
c. RBC autoantibody induction
d. Drug-induced nonimmunologic protein adsorption
11. A Group A Rh-negative mother gave birth to a Group O Rh-positive baby. The baby is at risk for HDFN if:
a. This was the mother’s first pregnancy
b. The mother has IgG ABO antibodies
c. The mother was previously immunized to the D antigen
d. The mother received Rh immune globulin prior to delivery
References
1. Jäger U, Lechner K. Autoimmune hemolytic anemia. In: Hoffman R, Benz E, Silberstein L, et al. Hoffman HematologyBasic Principles and Practice 6th ed. Philadelphia : Saunders, an imprint of Elsevier 2013 Accessed 23.03.13.
2. Leger R. The positive direct antiglobulin test and immune-mediated hemolysis. In: Roback J, Combs M, Grossman B, et al. Technical Manual. 17th ed. Bethesda, MD : American Association of Blood Banks 2011.
3. Mandle R, Barrington R, Carroll M. Complement and immunoglobulin biology. In: Hoffman R, Benz E, Jr. Silberstein L, et al. Hoffman HematologyBasic Principles and Practice 6th ed. Philadelphia : Saunders, an imprint of Elsevier 2013 Accessed 23.03.13.
4. Prodinger W, Würzner R, Stoiber H. Complement. In: Paul W. Fundamental Immunology. 6th ed. Philadelphia : Lippincott Williams & Wilkins 2008.
5. Friedberg R, Johari V. Autoimmune hemolytic anemia. In: Greer J, Foerster J, Rodgers G, et al. Wintrobe’s Clinical Hematology. 12th ed. Philadelphia : Lippincott Williams & Wilkins 2009.
6. Michel M. Classification and therapeutic approaches in autoimmune hemolytic anemia an update. Expert Rev Hematol; 2011; 4:607-618.
7. Dhingra K, Jain D, Mandal S, et al. Evans syndrome a study of six cases with review of literature. Hematology; 2008; 13:356-360.
8. Liu B, Gu W. Immunotherapy treatments of warm autoimmune hemolytic anemia. Clin Dev Immunol, 2013, 561852. Available at: doi: 10.1155/2013/561852 2013 Epub 2013 Sep 11.
9. Lechner K, Jäger U. How I treat autoimmune hemolytic anemia. Blood; 2010; 116:1831-1838.
10. Berentsen S, Beiske K, Tjonnfjord G. Primary chronic cold agglutinin disease an update on pathogenesis, clinical features and therapy. Hematology; 2007; 12:361-370.
11. Petz L. Cold antibody autoimmune hemolytic anemias. Blood Rev; 2008; 22:1-15.
12. Berentsen S, Ulvestad E, Langholm R, et al. Primary chronic cold agglutinin disease a population based clinical study of 86 patients. Haematologica; 2006; 91:460-466.
13. Berentsen S, Randen U, Vagan A, et al. High response rate and durable remissions following fludarabine and rituximab combination therapy for chronic cold agglutinin disease. Blood; 2010; 116:3180-3184.
14. Schöllkopf C, Kjeldsen L, Bjerrum O.W, et al. Rituximab in chronic cold agglutinin disease a prospective study of 20 patients. Leuk Lymphoma; 2006; 47:253-260.
15. Karafin M, Shirey S, Ness P, et al. A case study of a child with chronic hemolytic anemia due to a Donath-Landsteiner positive, IgM anti-I autoantibody. Pediatr Blood Cancer; 2012; 59:953-955.
16. Gertz M. Management of cold haemolytic syndrome. Br J Haematol; 2007; 138:422-429.
17. Sokol R, Hewitt S, Stamps B. Autoimmune haemolysis an 18 year study of 865 cases referred to a regional transfusion centre. Br Med J; 1981; 282:2023-2027.
18. Mayer B, Yurek S, Kiesewetter H, et al. Mixed-type autoimmune hemolytic anemia differential diagnosis and critical review of reported cases. Transfusion; 2008; 48:2229-2234.
19. Garratty G. Immune hemolytic anemia associated with drug therapy. Blood Rev; 2010; 24:143-150.
20. Johnson S, Fueger J, Gottschall J. One center’s experience the serology and drugs associated with drug-induced hemolytic anemia—a new paradigm. Transfusion; 2007; 47:697-702.
21. Garratty G. Drug-induced immune hemolytic anemia. : Hematology Am Soc Hematol Educ Program 2009; 73-79.
22. Garratty G, Arndt P. An update on drug-induced immune hemolytic anemia. Immunohematology; 2007; 23:105-119.
23. Gupta S, Piefer C, Fueger J, et al. Trimethoprim-induced immune hemolytic anemia in a pediatric oncology patient presenting as an acute hemolytic transfusion reaction. Pediatr Blood Cancer; 2010; 55:1201-1203.
24. Arndt P, Garratty G, Isaak E, et al. Positive direct and indirect antiglobulin tests associated with oxaliplatin can be due to drug antibody and/or drug-induced nonimmunologic protein adsorption. Transfusion; 2009; 49:711-718.
25. Salama A. Drug-induced immune hemolytic anemia. Expert Opin Drug Saf; 2009; 8:73-79.
26. Lichtman M. A, Kipps T. J, Seligsohn U, et al. Red cell transfusion. Available at: http://accessmedicine.mhmedical.com.libproxy2.umdnj.edu/content.aspx?bookid=358& Sectionid=39835965 In: Lerner N.B, Refaai M.A, Blumberg N. Williams Hematology. 8th ed. New York : McGraw-Hill 2010 Accessed 28.02.14.
27. Eder A, Chambers L. Noninfectious complications of blood transfusion. Arch Pathol Lab Med; 2007; 131:708-718.
28. Ramasethu J, Luban N.C. Alloimmune hemolytic disease of the fetus and newborn. Available at: http://accessmedicine.mhmedical.com.libproxy2.umdnj.edu/content.aspx?bookid=358& Sectionid=39835872 In: Lichtman M. A, Kipps T. J, Seligsohn U. Williams Hematology. 8th ed. New York : McGraw-Hill 2010 Accessed 28.02.14.
29. Koelewijn J, Haas M, Vrijkotte T, et al. One single dose of 200 mg of antenatal RhIG halves the risk of anti-D immunization and hemolytic disease of the fetus and newborn in the next pregnancy. Transfusion; 2008; 48:1721-1729.
30. Dodd J.M, Windrim R.C, van Kamp I.L. Techniques of intrauterine fetal transfusion for women with red-cell isoimmunisation for improving health outcomes. Cochrane Database Syst Rev Sept; 2012; 12:9 CD007096.
31. Patel L.L, Myers J.C, Palma J.P, et al. Anti-Ge3 causes late-onset hemolytic disease of the newborn the fourth case in three Hispanic families. Transfusion; 2013; 53:2152-2157.
32. Dorn I, Schlenke P, Hartel C. Prolonged anemia in an intrauterine-transfused neonate with Rh-negative hemolytic disease no evidence for anti-D-related suppression of erythropoiesis in vitro. Transfusion; 2010; 50:1064-1070.
33. Michalewska B, Wielgos M, Zupanska B, et al. Anti-Coa implicated in severe haemolytic disease of the foetus and newborn. Transfus Med; 2008; 18:71-73.
34. Dohmen S, Muit J, Ligthart P, et al. Anti-e found in a case of hemolytic disease of the fetus and newborn makes use of the IGHV3 superspecies genes. Transfusion; 2008; 48:194.
35. van Gammeren A.J, Overbeeke M.A, Idema R.N, et al. Haemolytic disease of the newborn because of rare anti-Vel. Transfus Med; 2008; 18:197-198.
36. Li B.J, Jiang Y.J, Yuan F, et al. Exchange transfusion of least incompatible blood for severe hemolytic disease of the newborn due to anti-Rh17. Transfus Med; 2010; 20:66-69.
37. Koelewijn J.M, Vrijkotte T.G, van der Schoot C.E, et al. Effect of screening for red cell antibodies, other than anti-D, to detect hemolytic disease of the fetus and newborn a population study in the Netherlands. Transfusion; 2008; 48:941-952.
*The author acknowledges the contributions to the framework and content of the chapter by Elaine M. Keohane, author of this chapter in the previous edition.